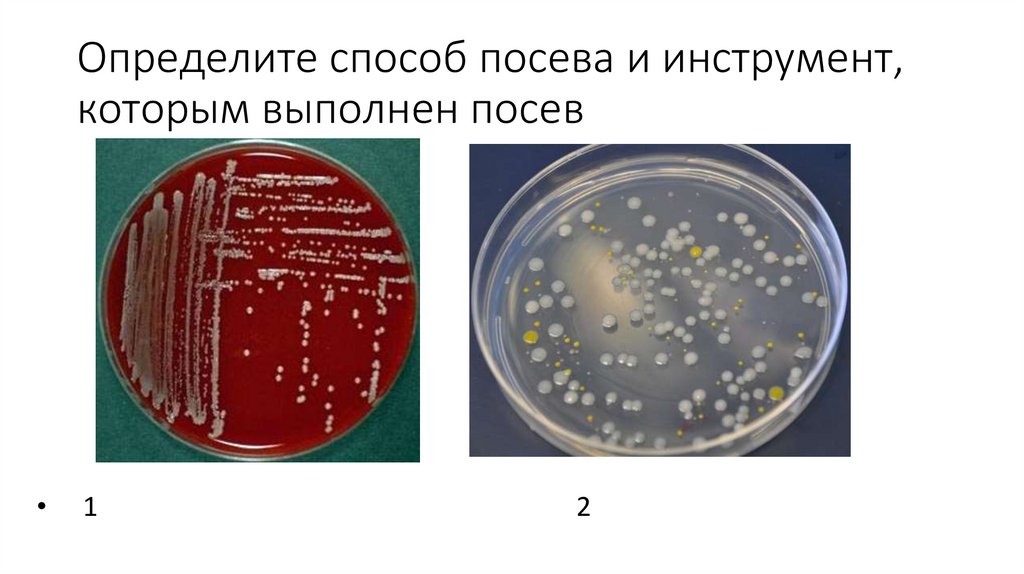
Определите способ посева и инструмент, которым выполнен посев

задание Физиология МО
1. Физиология МО. Задание
2.
• Определите по росту на жидкой питательной среде отношениямикроорганизма к кислороду
•1
2
3
3. По типу среды определите тип питания микроорганизма (автотроф, гетеротроф, вирус)
• 1. Живая культура клеток печени кролика• 2.
• 3 Среда Сабуро
4. Определите способ посева и инструмент, которым выполнен посев
1
2